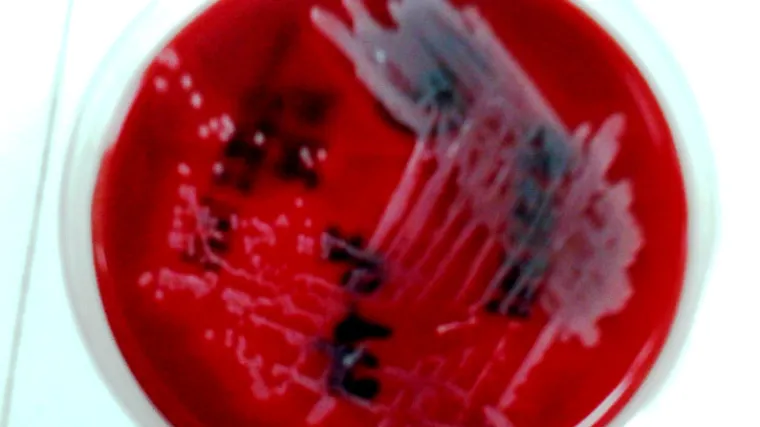
Znanstvenici tvrde da su pronašli način kako ubiti superbakteriju

Znanstvenici tvrde da su pronašli način kako ubiti superbakteriju
Znanstvenik Christopher Tan te njegove kolege iz istraživačkog laboratorija Merck iz New Jesrseya pronašli su način kako da bakterija MRSA ne bude više otporna na antibiotike, piše New Scientist
Tan te njegove kolege iz Istraživačkih laboratorija Merick iz New Jerseyja tvrde kako su uspjeli slomiti otpornost MRSA-e uz pomoć spojeva nazvanih tarocin A i tarocin B. Nakon što oni slome otpornost MRSA-e, bakterije se ubijaju antibioticima.
Ova velika vijest uskoro će pomoći smanjenju širenja MRSA-e po bolnicama, gdje je najveći uzročnik infekcija, a vrlo često ima smrtne posljedice.
Naime, ta bakterija dosad je bila otporna na široki spektar antibiotika, od meticilina do penicilina. Znanstvenici kažu kako su uspjeli dokazati efektivnost tarocina A i tarocina B na zaraženim laboratorijskim miševima, ali i na kliničim ispitivanjima. No, ovi kemijski spojevi još nisu testirani na ljudima.
Budućnost liječenja u razbijanju otpornosti bakterija
Kako piše New Scientist, ipak postoji jedan nedostatak u cijelom planu, a taj je da ako bi se samo tarocini koristili za ubijanje MRSA-e, postoji opasnost da bi se i na njih kroz neko vrijeme stvorila otpornost. No, znanstvenici misle kako bi se taj problem mogao riješiti uvođenjem trećeg lijeka u cijeli proces koji cilja još jedan dio zadužen za otpornost ove bakterije, piše New Scientist.
"Kako će nam trebati barem dvadesetak godina da bismo dobili neki broj novih antibiotika, moramo raditi na tome da ovi koje imamo budu što duže efektivni, a jedina šansa za to su ovakvi razbijači otpornosti bakterija", objasnio je David Brown iz britanske organizacije za istraživanja antibiotika. Slična strategija liječenja već se koristi kod oboljelih od e. coli te bakterijske upale pluća koju izazivaju organizmi.






















